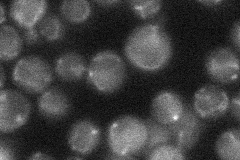
YHR059W
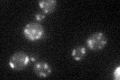
YHR059W

View description
Protein of unknown function, required for survival upon exposure to K1 killer toxin
Localization:
Intensity:
Fold change:
Significance:
-
C’ GFP library in SD

mitochondria36.06 -
N' NOP1pr-GFP in SD

mitochondria73.383 -
N' TEF2pr-mCherry in SD

mitochondria7.25927 -
N' NATIVEpr-GFP in SD
mitochondria19.413 -
N' TEF2pr-VC and Cyto-VN in SD

#N/A0 -
C’ GFP library in SD+DTT

mitochondria37.851.04No -
C’ GFP library in SD+H2O2
mitochondria29.050.8No -
C’ GFP library in Starvation Media

mitochondria25.160.69No -
C’ GFP library on the background of Pup2-DaMP

mitochondria -
C’ GFP library on the background of CCT mutant

mitochondria29.84510.827522No
